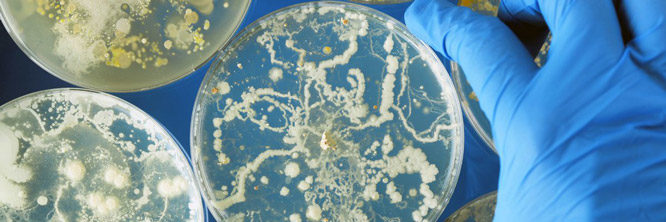

Pollen Count Dallas
890 780 tomorrow 729 3 ragweed pollen levels will be moderate.

Pollen count dallas. Or search by date. Dallas had the fifth highest pollen. Pollen and air quality forecast for dallas tx with air quality index pollutants pollen count and pollution map from weather underground.
Pollen breakdown covers specific pollens like ragweed while todays pollen count tracks all pollen. Allergen m 3 record high this day record high all time no data. The weather channels allergy tracker shows pollen counts ranging from high to very high through saturday before dropping to moderate for sunday and monday.
Grass pollen tree pollen mold. United states weather dallas tx 850 f allergies. We specialize in both medical issues and aesthetic improvement for the head and face.
Get 5 day allergy forecast for dallas tx 75201. Daily pollen count august 1 2020. The 15 day forecast covers more than pollen so even if pollen is low the overall allergy.
Get 30 day historic pollen levels for dallas tx 75201. The following aeroallergen network calculations are based on the data per cubic meter reported by all certified counting stations for trees grasses weeds and molds. See predominant allergens and allergy forecast discussion to better prepare for next day.
Get current allergy report for dallas tx 75201. See predominant allergens and allergy forecast discussion to better prepare for next day. Ragweed pollen levels will be moderate.
Todays pollen count for sunday august 2 2020. See predominant allergens and allergy forecast discussion to better prepare for next day.


/arc-anglerfish-arc2-prod-dmn.s3.amazonaws.com/public/JGYILENZ26QWA7MN2UHGBPQULI.jpg)






















/arc-anglerfish-arc2-prod-dmn.s3.amazonaws.com/public/BY4LD2FZH32SY6CLCT3MT5H4FU.jpg)
/arc-anglerfish-arc2-prod-dmn.s3.amazonaws.com/public/JT6HJYENVAULSGFQUJADLPJHE4.jpg)





















































/arc-anglerfish-arc2-prod-dmn.s3.amazonaws.com/public/7EHI7YE2PW7FNZYZ467V6RCRME.jpg)